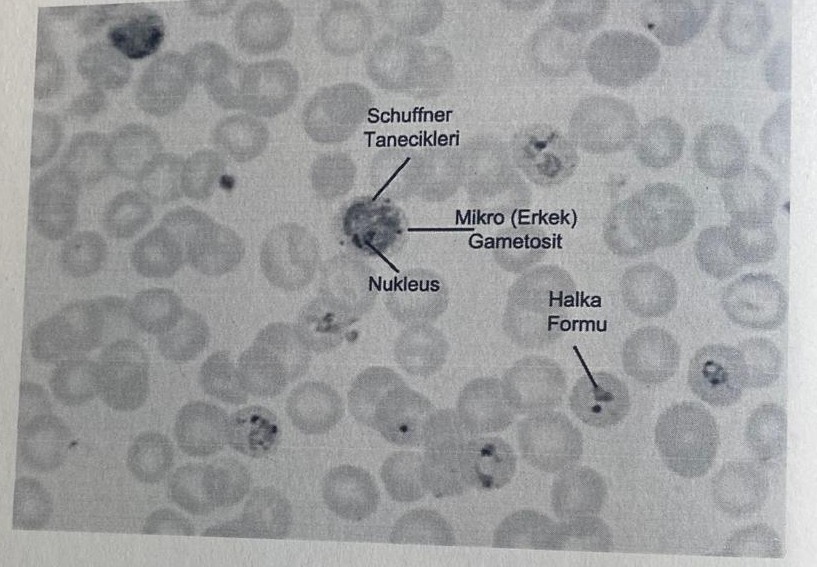
<img src="https://knowt-user-attachments.s3.amazonaws.com/a3725b65-587c-48cc-9272-696eb8b2f6f3.jpg" data-width="100%" data-align="center" alt="knowt flashcard image"><img src="https://knowt-user-attachments.s3.amazonaws.com/685c8b6d-900b-46f6-a622-472b80692b42.jpg" data-width="100%" data-align="center" alt="knowt flashcard image"><p></p>
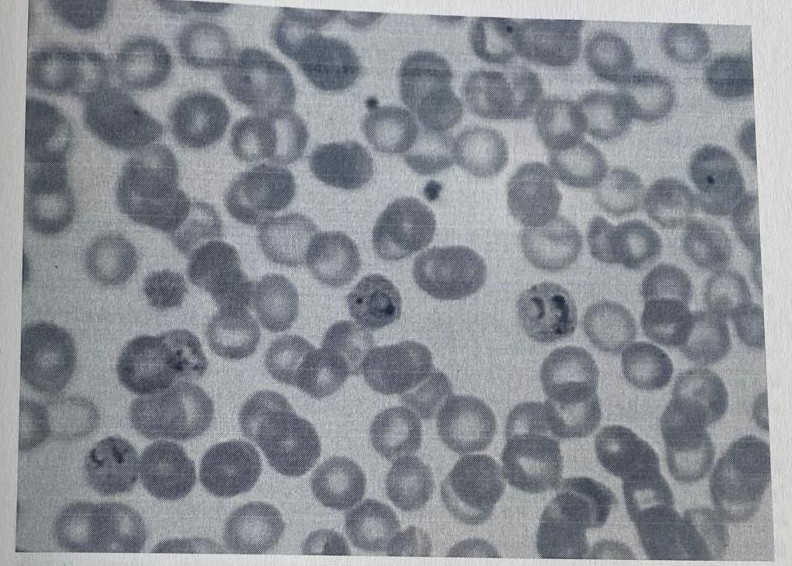
knowt flashcard image

1/73
Looks like no tags are added yet.
Name | Mastery | Learn | Test | Matching | Spaced | Call with Kai |
|---|
No analytics yet
Send a link to your students to track their progress

Regnum: Protista
Phylum: Dinoflagellata
Classis: Dinoflagellidea
Ordo: Diniferida
Genus: Ceratium
Ceratium huridinella

Regnum: Protista
Phylum: Dinoflagellata
Classis: Dinoflagellidea
Ordo: Diniferida
Genus: Noctiluca
Noctiluca miliaris



Regnum: Protista
Phylum: Mastigophora (Flagellata)
Classis: Kinetoplastidea
Ordo: Kinetoplastida
Genus: Trypanosoma

Regnum: Protista
Phylum: Mastigophora (Flagellata)
Classis: Diplomonadea
Ordo: Diplomonadida
Genus: Giardia
Gierdia intestinalis



Regnum: Protista
Phylum: Apicomplexa (Sporozoa)
Classis: Coccidea
Ordo: Eimeriida
Genus: Toxoplasma
Toxoplasma gondii

Regnum: Protista
Phylum: Apicomplexa (Sporozoa)
Classis: Hematozoea
Ordo: Haemosporida
Genus: Plasmodium
Plasmodium vivax

Regnum: Protista
Phylum: Ciliophora (Ciliata)
Classis: Litostomatea
Ordo: Trichostomatida
Genus: Isotricha

Regnum: Animalia
Phylum: Porifera (Parazoa, Spongiaria)
Classis: Demospongiae
Ordo: Hadromerina
Genus: Suberites
Suberites domuncula

Regnum: Animalia
Phylum: Porifera (Parazoa, Spongiaria)
Classis: Demospongiae
Ordo: Hadromerina
Genus: Tethya
Tethya aurantium

Regnum: Animalia
Phylum: Porifera (Parazoa, Spongiaria)
Classis: Demospongiae
Ordo: Poecilosclerina
Genus: Raspailia
Raspailia viminalis

Regnum: Animalia
Phylum: Porifera (Parazoa, Spongiaria)
Classis: Demospongiae
Ordo: Haplosclerina
Genus: Haliclona
Haliclona cratera

Regnum: Animalia
Phylum: Porifera (Parazoa, Spongiaria)
Classis: Demospongiae
Ordo: Keratosa
Genus: Spongia (Euspongia)
Spongia officinalis

Regnum: Animalia
Phylum: Porifera (Parazoa, Spongiaria)
Classis: Demospongiae
Ordo: Keratosa
Genus: Verongia (Euspongia)
Verongia aerophoba

Regnum: Animalia
Phylum: Cnidaria (Coelenterata)
Classis: Hydrozoa
Ordo: Leptomedusae
Genus: Obelia
Obelia dichotoma

Regnum: Animalia
Phylum: Cnidaria (Coelenterata)
Classis: Hydrozoa
Ordo: Anthomedusae
Genus: Tubularia

Regnum: Animalia
Phylum: Cnidaria (Coelenterata)
Classis: Scyphozoa
Ordo: Cubomedusae
Genus: Charybdea
Charybdea marsupialis



Regnum: Animalia
Phylum: Cnidaria (Coelenterata)
Classis: Scyphozoa
Ordo: Semaeostomae
Genus: Aurelia
Aurelia aurita

Regnum: Animalia
Phylum: Cnidaria (Coelenterata)
Classis: Scyphozoa
Ordo: Semaeostomae
Genus: Pelagia
Pelagia noctiluca

Regnum: Animalia
Phylum: Cnidaria (Coelenterata)
Classis: Scyphozoa
Ordo: Rhizostomae
Genus: Cotylorhiza
Cotylorhiza tuberculata

Regnum: Animalia
Phylum: Cnidaria (Coelenterata)
Classis: Scyphozoa
Ordo: Rhizostomaea
Genus: Rhizostoma
Rhizostoma pulmo

Regnum: Animalia
Phylum: Cnidaria (Coelenterata)
Classis: Anthozoa
Ordo: Alcyonacea
Genus: Alcyonium
Alcyonium palmatum

Regnum: Animalia
Phylum: Cnidaria (Coelenterata)
Classis: Anthozoa
Ordo: Pennatulacea
Genus: Veretillum
Veretillum cynomorium

Regnum: Animalia
Phylum: Cnidaria (Coelenterata)
Classis: Anthozoa
Ordo: Pennatulacea
Genus: Pennatula

Regnum: Animalia
Phylum: Cnidaria (Coelenterata)
Classis: Anthozoa
Ordo: Actinaria
Genus: Actinia

Regnum: Animalia
Phylum: Cnidaria (Coelenterata)
Classis: Anthozoa
Ordo: Actinaria
Genus: Anemonia
Anemonia sulcata

Regnum: Animalia
Phylum: Cnidaria (Coelenterata)
Classis: Anthozoa
Ordo: Madreporaria
Genus: Cladocora
Cladocora cespitosa



Regnum: Animalia
Phylum: Plathelminthes
Classis: Turbellaria
Ordo: Tricladida
Genus: Planaria



Regnum: Animalia
Phylum: Plathelminthes
Classis: Trematoda
Ordo: Echinostomata
Genus: Fasciola
Fasciola hepatica


Regnum: Animalia
Phylum: Plathelminthes
Classis: Cestoidea
Ordo: Cyclophyllidea
Genus: Taenia

Regnum: Animalia
Phylum: Nematoda (Nemathelminthes)
Classis: Adenophorea (Aphasmidia)
Ordo: Trichurida (Trichinellida)
Genus: Trichinella


Regnum: Animalia
Phylum: Nematoda (Nemathelminthes)
Classis: Secernentea (Phasmidia)
Ordo: Ascaridida
Genus: Ascaris
Ascaris lumbricoides

Regnum: Animalia
Phylum: Nematoda (Nemathelminthes)
Classis: Secernentea (Phasmidia)
Ordo: Ascaridida
Genus: Enterobius (Oxyuris)
Enterobius vermicularis


Regnum: Animalia
Phylum: Nematomorpha
Genus: Gordius

Regnum: Animalia
Phylum: Chaetognatha
Genus: Sagitta


Regnum: Animalia
Phylum: Rotatoria (Rotifera)
Classis: Monogononta
Ordo: Ploima
Genus: Brachionus

Regnum: Animalia
Phylum: Acanthocephala
Classis: Eoacanthocephala
Ordo: Neoechinorhynchidea
Genus: Neoechinorhynchus

Regnum: Animalia
Phylum: Annelida
Classis: Polychaeta
Subclassis: Errantia
Ordo: Phyllodocida
Genus: Laetmonice (Hermione)
Hermoine hystrix

Regnum: Animalia
Phylum: Annelida
Classis: Polychaeta
Subclassis: Errantia
Ordo: Phyllodocida
Genus: Hediste (Nereis)
Hediste diversicolor

Regnum: Animalia
Phylum: Annelida
Classis: Hirudinea
Ordo: Gnathobdellae
Genus: Hirudo
Hirudo medicinalis

Regnum: Animalia
Phylum: Mollusca
Classis: Cephalopoda
Subclassis: Nautiloidea (Tetrabranchiata)
Genus: Nautilus


Regnum: Animalia
Phylum: Mollusca
Classis: Cephalopoda
Subclassis: Coleoidea (Dibranchiata)
Ordo: Decabrachia
Genus: Sepia
Sepia officinalis

Regnum: Animalia
Phylum: Mollusca
Classis: Cephalopoda
Subclassis: Coleoidea (Dibranchiata)
Ordo: Decabrachia
Genus: Loligo
Loligo vulgaris

Regnum: Animalia
Phylum: Mollusca
Classis: Cephalopoda
Subclassis: Coleoidea (Dibranchiata)
Ordo: Octobrachia (Octopoda)
Genus: Octopus
Octopus vulgaris

Regnum: Animalia
Phylum: Mollusca
Classis: Polyplacophora
Genus: Chiton
Chiton olivaceus

Regnum: Animalia
Phylum: Mollusca
Classis: Gastropoda
Subclassis: Pulmonata
Ordo: Stylommatophora
Genus: Helix

Regnum: Animalia
Phylum: Mollusca
Classis: Gastropoda
Subclassis: Prosobranchia (Protobranchia)
Ordo: Archaeogastropoda
Genus: Patella

Regnum: Animalia
Phylum: Mollusca
Classis: Gastropoda
Subclassis: Prosobranchia (Protobranchia)
Ordo: Archaeogastropoda
Genus: Monodonta

Regnum: Animalia
Phylum: Mollusca
Classis: Gastropoda
Subclassis: Prosobranchia (Protobranchia)
Ordo: Archaeogastropoda
Genus: Haliotis

Regnum: Animalia
Phylum: Mollusca
Classis: Gastropoda
Subclassis: Prosobranchia (Protobranchia)
Ordo: Archaeogastropoda
Genus: Diodora

Regnum: Animalia
Phylum: Mollusca
Classis: Gastropoda
Subclassis: Prosobranchia (Protobranchia)
Ordo: Mesogastropoda
Genus: Melanopsis

Regnum: Animalia
Phylum: Mollusca
Classis: Gastropoda
Subclassis: Prosobranchia (Protobranchia)
Ordo: Mesogastropoda
Genus: Gourmya
Gourmya vulgata

Regnum: Animalia
Phylum: Mollusca
Classis: Gastropoda
Subclassis: Prosobranchia (Protobranchia)
Ordo: Mesogastropoda
Genus: Dolium (Tonna)

Regnum: Animalia
Phylum: Mollusca
Classis: Gastropoda
Subclassis: Prosobranchia (Protobranchia)
Ordo: Mesogastropoda
Genus: Aporrhais

Regnum: Animalia
Phylum: Mollusca
Classis: Gastropoda
Subclassis: Prosobranchia (Protobranchia)
Ordo: Neogastropoda
Genus: Murex
Murex brandaris

Regnum: Animalia
Phylum: Mollusca
Classis: Gastropoda
Subclassis: Prosobranchia (Protobranchia)
Ordo: Neogastropoda
Genus: Conus

Regnum: Animalia
Phylum: Mollusca
Classis: Gastropoda
Subclassis: Prosobranchia (Protobranchia)
Ordo: Neogastropoda
Genus: Columbella
Columbella rustica

Regnum: Animalia
Phylum: Mollusca
Classis: Gastropoda
Subclassis: Opistobranchia
Ordo: Anaspidea
Genus: Aplysia

Regnum: Animalia
Phylum: Mollusca
Classis: Lamellibranchia (Bivalvia)
Subclassis: Pteriomorpha
Ordo: Filibranchia
Genus: Arca
Arca noae

Regnum: Animalia
Phylum: Mollusca
Classis: Lamellibranchia (Bivalvia)
Subclassis: Pteriomorpha
Ordo: Filibranchia
Genus: Pinna
Pinna nobilis

Regnum: Animalia
Phylum: Mollusca
Classis: Lamellibranchia (Bivalvia)
Subclassis: Pteriomorpha
Ordo: Filibranchia
Genus: Ostrea
Ostrea edulis

Regnum: Animalia
Phylum: Mollusca
Classis: Lamellibranchia (Bivalvia)
Subclassis: Pteriomorpha
Ordo: Filibranchia
Genus: Pecten
Pecten jacobaeus

Regnum: Animalia
Phylum: Mollusca
Classis: Lamellibranchia (Bivalvia)
Subclassis: Pteriomorpha
Ordo: Filibranchia
Genus: Chlamys
Chlamys varia

Regnum: Animalia
Phylum: Mollusca
Classis: Lamellibranchia (Bivalvia)
Subclassis: Heterodonta
Ordo: Eulamellibranchia
Genus: Rudicardium (Cardium)
Rudicardium tuberculatum

Regnum: Animalia
Phylum: Mollusca
Classis: Lamellibranchia (Bivalvia)
Subclassis: Heterodonta
Ordo: Eulamellibranchia
Genus: Venus
Venus verrucosa

Regnum: Animalia
Phylum: Mollusca
Classis: Lamellibranchia (Bivalvia)
Subclassis: Heterodonta
Ordo: Eulamellibranchia
Genus: Venerupis (Tapes)
Venerupis decussata

Regnum: Animalia
Phylum: Mollusca
Classis: Lamellibranchia (Bivalvia)
Subclassis: Heterodonta
Ordo: Eulamellibranchia
Genus: Donax
Donax vittatus

Regnum: Animalia
Phylum: Mollusca
Classis: Lamellibranchia (Bivalvia)
Subclassis: Heterodonta
Ordo: Eulamellibranchia
Genus: Solen
Solen marginatus

Regnum: Animalia
Phylum: Echinodermata
Classis: Astroidea
Genus: Astropecten
Astropecten aranciacus

Regnum: Animalia
Phylum: Echinodermata
Classis: Astroidea
Genus: Sphaerodiscus (Ceramaster)
Ceramaster placenta

Regnum: Animalia
Phylum: Echinodermata
Classis: Echinoidea
Grup: Regularia
Genus: Sphaerechinus
Sphaerechinus granularus


Regnum: Animalia
Phylum: Echinodermata
Classis: Echinoidea
Grup: Irregularia
Genus: Brissus
Brissus unicolor

Regnum: Animalia
Phylum: Echinodermata
Classis: Ophiuroidea
Genus: Ophiura
Ophiura textura

Regnum: Animalia
Phylum: Echinodermata
Classis: Holothuroidea
Genus: Holothuria
Holothuria tubulosa

Regnum: Animalia
Phylum: Echinodermata
Classis: Crinoidea
Genus: Antedon
Antedon mediterranea